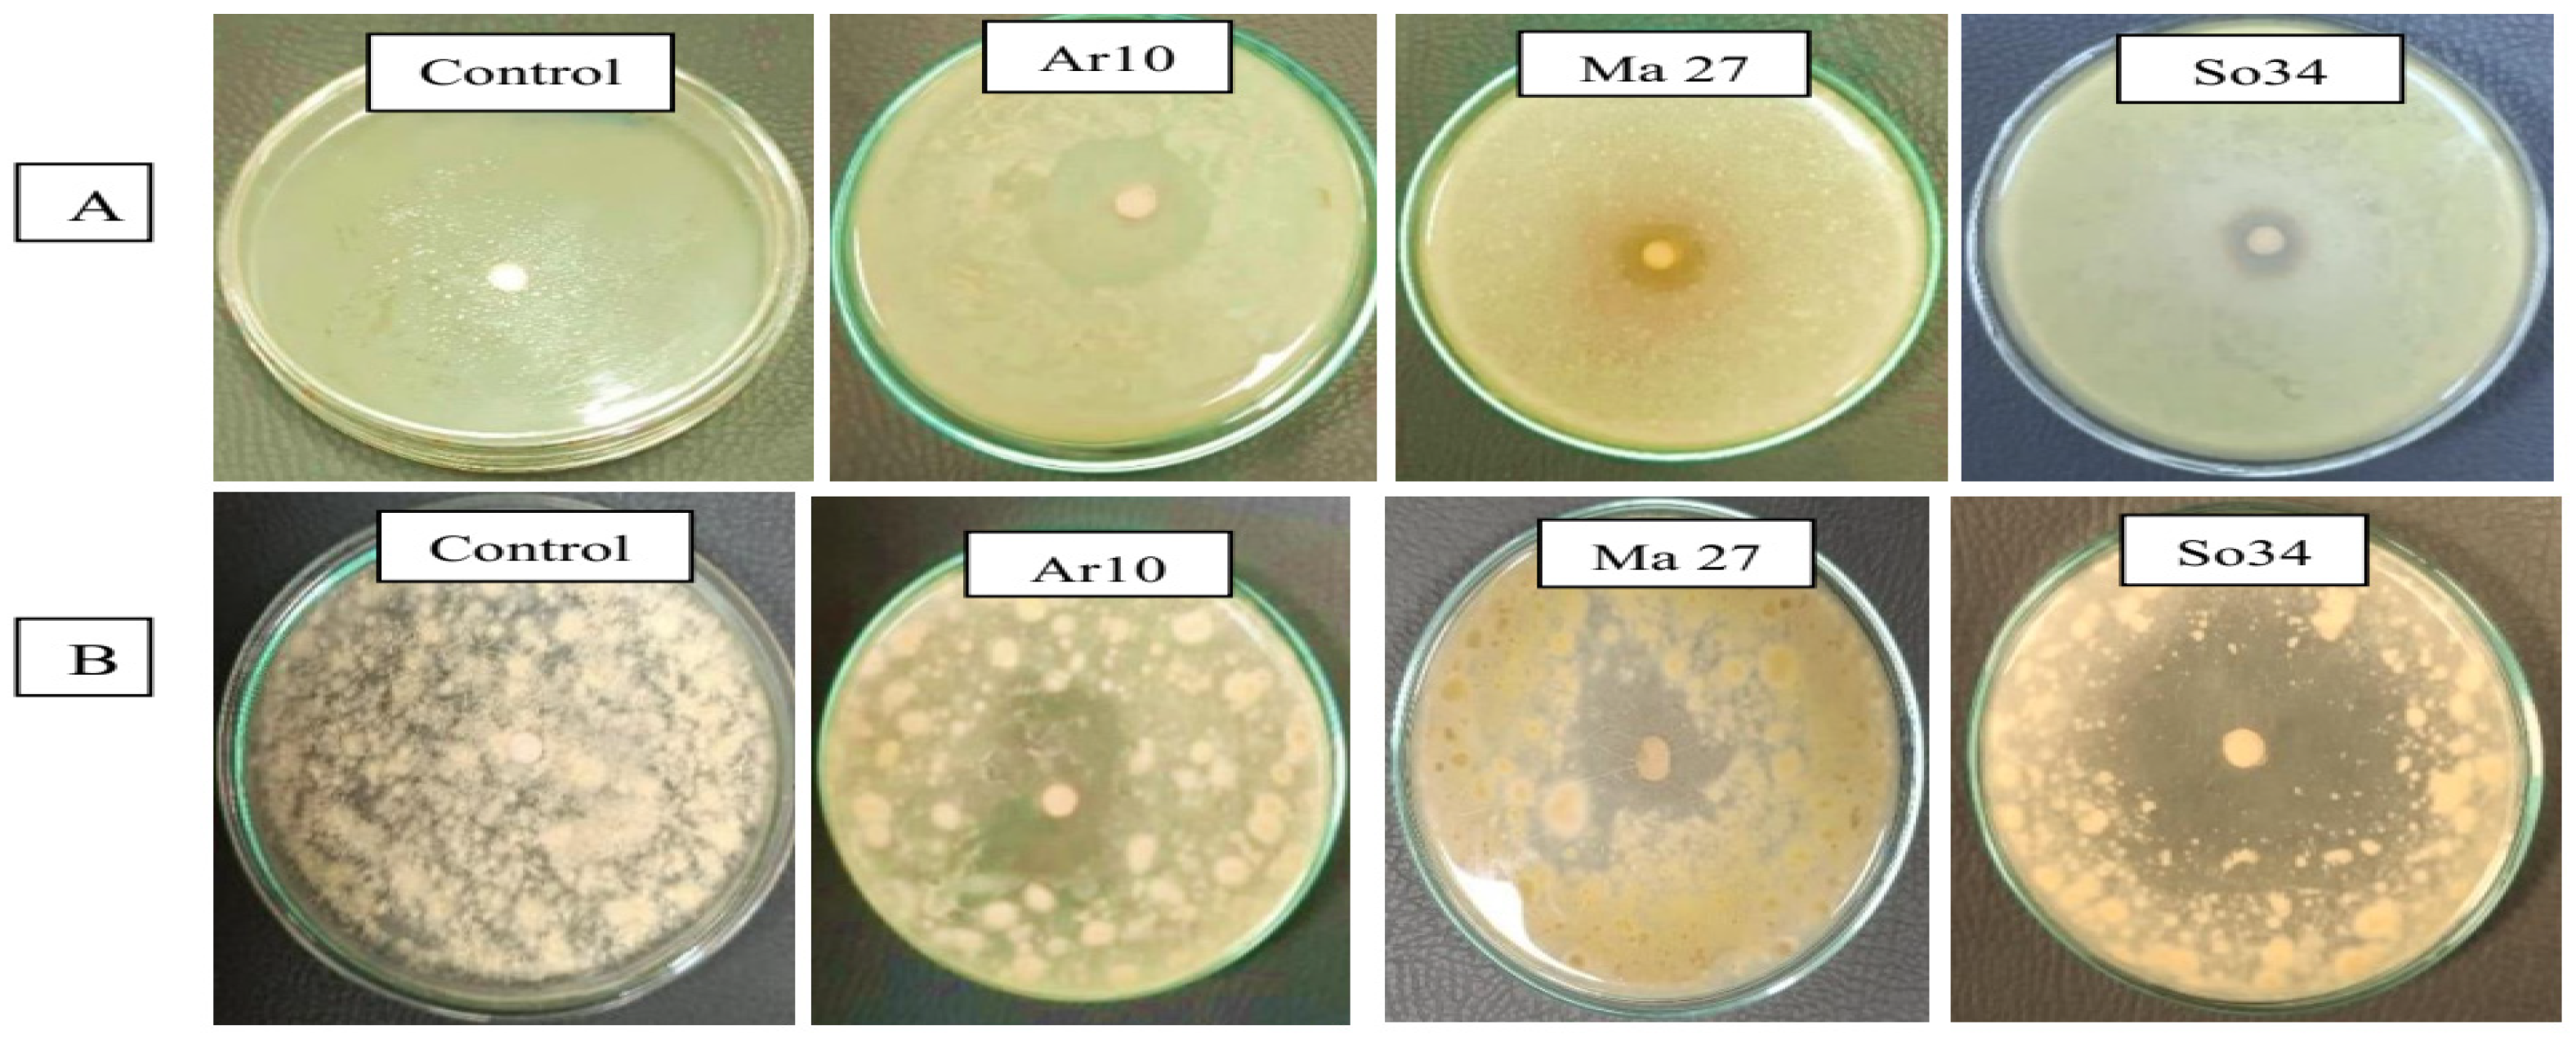

Endophytic Microbiome Is a Unique Repository of Bio-Foes Against Toxigenic Fungi Harming Peanut Productivity
Abstract
1. Introduction
2. Materials and Methods
2.1. Soil
2.2. Peanut Pod Samples
2.3. Enumeration and Isolation of Toxin-Producing Fungi
2.4. Toxin-Producing Ability of Aspergillus spp. Isolates
2.5. Pathogenicity of Selected Aspergillus spp. Isolates Towards Peanut
2.6. Quantification of the Aflatoxigenic and Ochratoxigenic Potentials of Selected Pathogenic Fungal Isolates
2.7. Morphological Features of the Extremely Toxigenic Aspergillus spp. Isolates
2.8. Source and Isolation of Endophytic Bacteria
2.9. Antibiosis Potentials of Endophytes Against Aspergillus spp. Isolates
2.10. Molecular Identification of Selected Toxigenic Fungi and Endophytic Antagonists
2.11. Plant Growth-Promoting Activities of Identified Endophytic Bacteria
- 1.
- Indole acetic acid production:The indole acetic acid content was determined according to Bric et al. [52] with modifications. Bacterial endophytes were grown in nutrient broth containing 1 mM tryptophan at 28 °C for 3 days. After centrifugation, the supernatant was mixed with orthophosphoric acid and Salkowski’s reagent. The pink color developed was measured at 530 nm, and IAA concentration was determined using a standard curve.
- 2.
- Phosphate dissolving efficiency:Bacterial endophytes were qualitatively screened for phosphate solubilization by inoculating them on modified pikoviskaya agar medium. The formation of a clear zone around the colonies was observed after an incubation at 30 °C for 4 days was estimated. Quantitative estimation was carried out by inoculating 1 mL of bacterial suspension into Bunt and Rovira broth medium supplemented with 0.9 g rock phosphate per 100 cm3 medium. The cultures were incubated at 30 °C for 10 days, then centrifuged at 6000 rpm for 15 min, and the supernatant was then used to determine the concentration of dissolved following the method adopted of [53].
- 3.
- HCN production:HCN production was assessed following Geetha et al. [54]. King’s B agar medium supplemented with 4.4 g/L glycine was sterilized and poured into plates. Each isolate was streaked in triplicate plates. Whatman No. 1 filter paper pads soaked in 2 mL of picric acid solution (12.5 g/L Na2Co3, 2.5 g/L picric acid) were placed on plate lids. The plates were sealed with parafilm and incubated at 30 °C for 7 days. HCN production was evaluated based on color change in the filter paper: no change (−), brown (+), brownish-orange (++) or complete orange (++++), indicating increasing HCN levels.
- 4.
- Production of exo-polysaccharides (EPS):Endophytes were cultured in sucrose broth medium at 30 °C. After incubation, cells were centrifuged at 6000 rpm in 1 Mm EDTA. The supernatant was mixed with equal volume of cold acetone to precipitate EPS. The precipitate was collected by centrifugation at 6000 rpm for 30 min, dried at 60 °C and weighed as described by [55].
2.12. Afla-/Ochratoxin Degradation by Endophytic Bacterial Strains
2.13. The Endophyte–Pathogen Interweave Affecting Peanut Seedling Development
2.14. Statistical Analysis
3. Results
3.1. Disease Attributes of Fungi-Infected Peanut Pods
3.2. Prevalence of Toxigenic Aspergillus spp. Infecting Peanut Pods
3.3. Quantitative Production of Aflatoxin B1 (AFB1) and Ochratoxin A (OTA) by Toxigenic Aspergillus spp.
3.4. Morphological Features and Molecular Identification of AFB1- and OTA-Producing Isolates
3.5. Endophytic Microbiome of Medicinal Plants
3.6. Taxonomic Position of Selected Endophytic Bacterial Isolates
3.7. Plant Growth-Promoting Properties of the Endophytes
3.8. Biodegradation of Fungal Toxins by Endophytic Bacterial Strains
3.9. Endophytic Antagonists/Toxigenic Fungi/Peanut Panorama in Gnotobiotic System
3.10. Endophytes and Fungi Populations in Legume Root Environment
3.11. Peanut Seedling Growth Parameters in Presence of Microbial Communities
4. Discussion
5. Conclusions
Supplementary Materials
Author Contributions
Funding
Institutional Review Board Statement
Informed Consent Statement
Data Availability Statement
Conflicts of Interest
References
- González-Curbelo, M.Á.; Kabak, B. Occurrence of mycotoxins in dried fruits worldwide, with a focus on aflatoxins and ochratoxin A: A Review. Toxins 2023, 15, 576. [Google Scholar] [CrossRef] [PubMed]
- Mukhtar, K.; Nabi, B.G.; Ansar, S.; Bhat, Z.F.; Aadil, R.M.; Mousavi Khaneghah, A. Mycotoxins and consumers awareness: Recent progress and future challenges. Toxicon 2023, 232, 107227. [Google Scholar] [CrossRef] [PubMed]
- Akinde, S.B.; Olaitan, J.O.; Ajayi, E.I.; Adeniyi, M.A. Fungal quality and molecular characterization of aflatoxin-producing Aspergillus species in irrigation water and fresh vegetables in southwest Nigeria. Jordan J. Agri. Sci. 2018, 14, 1. [Google Scholar]
- McCormick, S.P. Microbial Detoxification of Mycotoxins. J. Chem. Ecol. 2013, 39, 907–918. [Google Scholar] [CrossRef]
- Yu, J. Current understanding on aflatoxin biosynthesis and future perspective in reducing aflatoxin contamination. Toxins 2012, 4, 1024–1057. [Google Scholar] [CrossRef]
- Azzoune, N.; Mokrane, S.; Riba, A.; Bouras, N.; Verheecke, C.; Sabaou, N.; Mathieu, F. Contamination of common spices by aflatoxigenic fungi and aflatoxin B1 in Algeria. Qual. Assur. Saf. Crops Foods 2016, 8, 137–144. [Google Scholar] [CrossRef]
- Agriopoulou, S.; Stamatelopoulou, E.; Varzakas, T. Advances in occurrence, importance and mycotoxin control strategies: Prevention and detoxification in foods. Foods 2020, 9, 137. [Google Scholar] [CrossRef]
- Khan, R.; Ghazali, F.M.; Mahyudin, N.A.; Samsudin, N.P. Morphological characterization and determination of aflatoxigenic and non-aflatoxigenic Aspergillus flavus isolated from sweet corn kernels and soil in Malaysia. Agriculture 2020, 10, 450. [Google Scholar] [CrossRef]
- Birck, N.M.M.; Lorini, I.; Scussel, V.M. Fungus and mycotoxins in wheat grain at post-harvest. In Proceedings of the 9th International Working Conference on Stored Product Protection, Campinas, Brazil, 15–18 October 2006; pp. 198–205. [Google Scholar]
- Sangare, L.; Zhao, Y.; Folly, Y.; Chang, J.; Li, J.; Selvaraj, J.; Xing, F.; Zhou, L.; Wang, Y.; Liu, Y. Aflatoxin B1 Degradation by a Pseudomonas Strain. Toxins 2014, 6, 3028. [Google Scholar] [CrossRef]
- Adebo, O.A.; Njobeh, P.B.; Mavumengwana, V. Degradation and detoxification of AFB 1 by Staphylocococcus warneri, Sporosarcina sp. and Lysinibacillus fusiformis. Food Cont. 2016, 68, 92–96. [Google Scholar] [CrossRef]
- Alshannaq, A.; Yu, J.H. Occurrence, toxicity and analysis of major mycotoxins in food. Int. J. Environ. Res. Public Health 2017, 14, 632. [Google Scholar] [CrossRef] [PubMed]
- Van der Merwe, K.J.; Steyn, P.S.; Fourie, L.; Scott, D.B.; Theron, J.J. Ochratoxin A, a toxic metabolite produced by Aspergillus ochraceus Wilh. Nature 1965, 205, 1112–1113. [Google Scholar] [CrossRef]
- Ben Miri, Y.; Benabdallah, A.; Chentir, I.; Djenane, D.; Luvisi, A.; De Bellis, L. Comprehensive insights into ochratoxin A: Occurrence, analysis and control strategies. Foods 2024, 13, 1184. [Google Scholar] [CrossRef]
- Jonatova, P.; Dzuman, Z.; Prusova, N.; Hajslova, J.; Stranska-Zachariasova, M. Occurrence of ochratoxin A and its stereoisomeric degradation product in various types of coffee available in the Czech market. World Mycotoxin J. 2020, 13, 97–107. [Google Scholar] [CrossRef]
- Silva, L.J.G.; Teixeira, A.C.; Pereira, A.M.P.T.; Pena, A.; Lino, C.M. Ochratoxin A in beers marketed in portugal: Occurrence and human risk assessment. Toxins 2020, 12, 249. [Google Scholar] [CrossRef]
- Torović, L.; Lakatoš, I.; Majkić, T.; Beara, I. Risk to public health related to the presence of ochratoxin A in wines from Fruška Gora. LWT 2020, 129, 109537. [Google Scholar] [CrossRef]
- Carballo, D.; Fernández-Franzón, M.; Ferrer, E.; Pallarés, N.; Berrada, H. Dietary exposure to mycotoxins through alcoholic and non-alcoholic beverages in Valencia, Spain. Toxins 2021, 13, 438. [Google Scholar] [CrossRef]
- Nikolchina, I.; Rodrigues, P. A Preliminary study on microbiota and ochratoxin a contamination in commercial palm dates (Phoenix dactylifera). Mycotoxin Res. 2021, 37, 215–220. [Google Scholar] [CrossRef]
- Celik, D.; Kabak, B. Assessment to propose a maximum permitted level for ochratoxin A in dried figs. J. Food Compos. Anal. 2022, 112, 104705. [Google Scholar] [CrossRef]
- Delfino, D.; Lucchetti, D.; Mauti, T.; Mancuso, M.; Di Giustino, P.; Triolone, D.; Vaccari, S.; Bonanni, R.C.; Neri, B.; Russo, K. Investigation of ochratoxin A in commercial cheeses and pork meat products by liquid chromatography-tandem mass spectrometry. J. Food Sci. 2022, 87, 4465–4475. [Google Scholar] [CrossRef]
- Wafula, E.N.; Muhonja, C.N.; Kuja, J.O.; Owaga, E.E.; Makonde, H.M.; Mathara, J.M.; Kimani, V.W. Lactic acid bacteria from African fermented cereal-based products: Potential biological control agents for mycotoxins in Kenya. J. Toxicol. 2022, 2397767. [Google Scholar] [CrossRef] [PubMed]
- Chang, P.K.; Hua, S.S. Non aflatoxigenic Aspergillus flavus TX9-8 competitively prevents aflatoxin accumulation by A. flavus isolates of large and small sclerotial morphotypes. Int. J. Food Microbiol. 2007, 114, 275–279. [Google Scholar] [CrossRef] [PubMed]
- Hormisch, D.; Hormisch, D.; Brost, I.; Kohring, G.W.; Giffhorn, F.; Kroppenstedt, R.M.; Stackebradt, E.; Färber, P.; Holzapfel, W.H. Mycobacterium fluoranthenivorans sp. nov.; a fluoranthene and aflatoxin B1 degrading bacterium from contaminated soil of a former coal gas plant. Syst. Appl. Microbiol. 2004, 27, 653–660. [Google Scholar] [CrossRef] [PubMed]
- Alberts, J.F.; Engelbrecht, Y.; Steyn, P.S.; Holzapfel, W.H.; van Zyl, W.H. Biological degradation of aflatoxin B1 by Rhodococcus erythropolis cultures. Int. J. Food Microbiol. 2006, 109, 121–126. [Google Scholar] [CrossRef]
- Samuel, M.S.; Sivaramakrishna, A.; Mehta, A. Degradation and detoxification of aflatoxin B1 by Pseudomonas putida. Int. Biodeter. Biodegr. 2014, 86, 202–209. [Google Scholar] [CrossRef]
- Harkai, P.; Szabó, I.; Cserháti, M.; Krifaton, C.; Risa, A.; Radó, J.; Balázs, A.; Berta, K.; Kriszt, B. Biodegradation of aflatoxin-B1 and zearalenone by Streptomyces sp. collection. Int. Biodeter. Biodegr. 2016, 108, 48–56. [Google Scholar] [CrossRef]
- Prettl, Z.; Dési, E.; Lepossa, A.; Kriszt, B.; Kukolya, J.; Nagy, E. Biological degradation of aflatoxin B1 by a Rhodococcus pyridinivorans strain in by-product of bioethanol. Anim. Feed Sci. Technol. 2017, 224, 104–114. [Google Scholar] [CrossRef]
- Adebo, O.A.; Njobeh, P.B.; Sidu, S.; Adebiyi, J.A.; Mavumengwana, V. Aflatoxin B1 degradation by culture and lysate of a Pontibacter sp. Food Cont. 2017, 80, 99–103. [Google Scholar] [CrossRef]
- Afsah-Hejri, L. Saprophytic yeasts: Effective biocontrol agents against Aspergillus flavus. Int. Food Res. J. 2013, 20, 3403–3409. [Google Scholar]
- Xia, X.; Zhang, Y.; Li, M.; Garba, B.; Zhang, Q.; Wang, Y.; Zhang, H.; Li, P. Isolation and characterization of a Bacillus subtilis strain with aflatoxin B1 biodegradation capability. Food Cont. 2017, 75, 92–98. [Google Scholar] [CrossRef]
- Raksha, R.K.; Vipin, A.V.; Hariprasad, P.; Anu Appaiah, K.A.; Venkateswaran, G. Biological detoxification of Aflatoxin B1 by Bacillus licheniformis CFR1. Food Cont. 2017, 71, 234–241. [Google Scholar] [CrossRef]
- Meneely, J.P.; Kolawole, O.; Haughey, S.A.; Sarah, J.; Miller, S.J.; Rudolf Krska, R.; Christopher, T.; Elliott, C.T. The challenge of global aflatoxins legislation with a focus on peanuts and peanut products: A systematic review. Expo. Health 2023, 15, 467–487. [Google Scholar] [CrossRef]
- Chen, L.; Shi, H.; Heng, J.; Wang, D.; Bian, K. Antimicrobial, plant growth-promoting and genomic properties of the peanut endophyte Bacillus velezensis LDO2. Microbiol. Res. 2019, 218, 41–48. [Google Scholar] [CrossRef] [PubMed]
- Liu, H.; Carvalhais, L.C.; Crawford, M.; Singh, E.; Dennis, P.G.; Pieterse, C.M.J.; Schenk, P.M. Inner plant values: Diversity, colonization and benefits from endophytic bacteria. Front. Microbiol. 2017, 8, 2552. [Google Scholar] [CrossRef] [PubMed]
- Ren, X.; Zhang, Q.; Zhang, W.; Mao, J.; Li, P. Control of aflatoxigenic molds by antagonistic microorganisms: Inhibitory behaviors, bioactive compounds, related mechanisms, and influencing factors. Toxins 2020, 12, 24. [Google Scholar] [CrossRef]
- Carter, M.R.; Gregorich, E.G. Soil Sampling and Methods of Analysis; CRC Press: Boca Raton, FL, USA, 2007; Available online: https://www.aweimagazine.com (accessed on 1 January 2023).
- Corry, J.E.L.; Curtis, G.D.W.; Baird, R.M. Handbook of culture media for food microbiology. Progress in Industrial Microbiology, 3rd ed.; Elsevier Sci. B.V.: Amsterdam, The Netherlands, 2003; Volume 37, ISBN 0-444-51084-2. [Google Scholar]
- Hoque, J.; Shamsi, S. Study of fungi associated with some selected vegetables of Dhaka City. Bangladesh J. Sci. Res. 2011, 24, 181–184. [Google Scholar] [CrossRef]
- Zrari, T.J.O. Detection of aflatoxin from some Aspergillus sp. isolated from wheat seeds. J. Life Sci. 2013, 7, 1041–1047. [Google Scholar]
- Davis, N.D.; Iyer, S.K.; Diener, U.L. Improved method of screening for aflatoxin with a coconut agar medium. Appl. Environ. Microbiol. 1987, 53, 1593–1595. [Google Scholar] [CrossRef]
- Liang, X.Q.; Holbrook, C.C.; Lynch, R.C.; Guo, B.Z. β-1,3-Glucanase activity in peanut seeds (Arachis hypogaea) is induced by inoculation with Aspergillus flavus and Copuriflies with a conglutun-like protein. Amer. Phytopathol. Soc. 2005, 95, 5–10. [Google Scholar] [CrossRef]
- Huang, L.; Duan, C.; Zhao, Y.; Gao, L.; Niu, C.; Xu, J.; Li, S. Reduction of aflatoxin B 1 toxicity by Lactobacillus plantarum C88: A potential probiotic strain isolated from Chinese traditional fermented food “tofu”. PLoS ONE 2017, 12, e0170109. [Google Scholar] [CrossRef]
- Mohale, S.; Magan, N.; Medina, A. Comparison of growth, nutritional utilization patterns and niche overlap indices of toxigenic and atoxigenic Aspergillus flavus strains. Fungal Biol. 2013, 117, 650. [Google Scholar] [CrossRef] [PubMed]
- AOAC. Official Methods of Analysis, 20th ed.; AOAC International: Gaithersburg, MD, USA, 2016; Chapter 49; no. 991.31. [Google Scholar]
- Pitt, A.; Hocking, J.I. Fungi and Food Spoilage; Springer: New York, NY, USA, 2009; pp. 1–519. [Google Scholar] [CrossRef]
- Silva, D.M.; Batista, L.R.; Rezende, E.F.; Fungaro, M.H.P.; Sartori, D.; Alves, E.E. Identification of fungi of the genus Aspergillus section nigri using polyphasic taxonomy. Braz. J. Microbiol. 2011, 42, 761–773. [Google Scholar] [CrossRef] [PubMed]
- Guan, S.; Ji, C.; Zhou, T.; Li, J.; Ma, Q.; Niu, T. Aflatoxin B1 degradation by Stenotrophomonas maltophilia and other microbes selected using coumarin medium. Int. J. Mol. Sci. 2008, 9, 1489. [Google Scholar] [CrossRef]
- Cappuccino, J.G.; Sherman, N. Microbiology: A Laboratory Manual, 10th ed.; Pearson Education, Inc.: Boston, MA, USA, 2014. [Google Scholar]
- Mardanova, A.M.; Hadieva, G.F.; Lutfullin, M.T.; Khilyas, I.V.; Minnullina, L.F.; Gilyazeva, A.G.; Bogomolnaya, L.M.; Sharipova, M.R. Bacillus subtilis strains with antifungal activity against the phytopathogenic fungi. Agri. Sci. 2017, 8, 1–20. [Google Scholar]
- Tamura, K.; Stecher, G.; Kumar, S. MEGA11: Molecular evolutionary genetics analysis version 11. Mol. Biol. Evol. 2021, 38, 3022–3027. [Google Scholar] [CrossRef]
- Birck, J.M.; Bostock, R.M.; Silverstone, S.E. Rapid in situ assay for indole acetic acid productionby bacteria immobilized on a nitrocellulose membrane. Appl. Environ. Microbiol. 1991, 57, 535–538. [Google Scholar]
- Nautiyal, C.S. An efficient microbiological growth medium for screening phosphate solubilizing microorganisms. FEMS. Microbiol. Lett. 1999, 170, 265–270. [Google Scholar] [CrossRef]
- Geetha, K.; Venkatesham, E.; Hindumathi, A.; Bhadraiah, B. Isolation, screening and characterization of plant growth promoting bacteria and their effect on Vigna Radita (L.) R. Wilczek. Int. J. Curr. Microbiol. Appl. Sci. 2014, 3, 799–803. [Google Scholar]
- Emtiazi, G.; Ethemadifara, Z.; Habib, M.H. Production of extra-cellular polymer in Azotobacter and biosorption of metal by exopolymer. Afr. J. Biotechnol. 2004, 3, 330–333. [Google Scholar]
- Kocić-Tanackov, S.; Dimić, G.; Tanackov, I.; Pejin, D. The inhibitory effect of oregano extract on the growth of Aspergillus spp. and on sterigmatocystin biosynthesis. LWT—Food Sci. Technol. 2012, 49, 14–20. [Google Scholar] [CrossRef]
- Hoagland, D.R.; Arnon, D. The Water-Culture Method for Growing Plants without Soil; California Agricultural Experiment Station: Berkeley, CA, USA, 1950. [Google Scholar]
- Hardle, W.; Simar, L. Applied Multivariate Statistical Analysis; Springer: Berlin/Heidelberg, Germany, 2003; ISBN 978-3-540-03079-9. [Google Scholar]
- Caceres, I.; Snini, S.P.; Puel, O.; Mathieu, F. Streptomyces roseolus: A promising biocontrol agent against Aspergillus flavus, the main aflatoxin B1 producer. Toxins 2018, 10, 442. [Google Scholar] [CrossRef] [PubMed]
- Abdel-Nasser, A.; Badr, A.N.; Fathy, H.M.; Ghareeb, M.A.; Barakat, O.S.; Hathout, A.S. Antifungal, antiaflatoxigenic and cytotoxic properties of bioactive secondary metabolites derived from Bacillus sp. Sci. Rep. 2024, 14, 16590. [Google Scholar] [CrossRef]
- Liu, Y.; Teng, K.; Wang, T.; Dong, E.; Zhang, M.; Tao, Y.; Zhong, J. Antimicrobial Bacillus velezensis HC6: Production of three kinds of lipopeptides and biocontrol potential in maize. J. Appl. Microbiol. 2020, 128, 242–254. [Google Scholar] [CrossRef]
- Hellany, H.; Assaf, J.C.; Matta, J.; Mahmoud, I.; Khalil, M.I. Fungal isolation, detection and quantification of aflatoxins in Nuts Sold in the Lebanese market. Processes 2024, 12, 1018. [Google Scholar] [CrossRef]
- Williams, J.H.; Phillips, T.D.; Jolly, P.E.; Stiles, J.K.; Jolly, C.M.; Aggarwal, D. Human aflatoxicosis in developing countries: A review of toxicology, exposure, potential health consequences, and interventions. Am. J. Clin. Nutr. 2004, 80, 1106–1122. [Google Scholar] [CrossRef]
- Lee, B.H.; Huang, C.H.; Liu, T.Y.; Liou, J.S.; Hou, C.Y.; Hsu, W.H. Microbial diversity of anaerobic-fermented coffee and potential for inhibiting ochratoxin-produced Aspergillus niger. Foods 2023, 12, 2967. [Google Scholar] [CrossRef]
- Mavioglu, K.M.; Deveci, H.A.; Kaya, I.; Atar, N.; Yola, M.L. The electrochemical detection of ochratoxin in An apple juice via MnCO3 nanostructures incorporated into carbon fibers containing a molecularly imprinting polymer. Biosensors 2023, 13, 760. [Google Scholar] [CrossRef]
- Topi, D.; Babič, J.; Jakovac-Strajn, B.; Tavčar-Kalcher, G. Incidence of aflatoxins and ochratoxin A in wheat and corn from Albania. Toxins 2023, 15, 567. [Google Scholar] [CrossRef]
- Schrenk, D.; Bodin, L.; Chipman, J.K.; del Mazo, J.; Grasl-Kraupp, B.; Hogstrand, C.; Hoogenboom, L.; Leblanc, J.C.; Nebbia, C.S. Scientific opinion on the risk assessment of ochratoxin A in food. EFSA J. 2020, 18, 6113. [Google Scholar]
- Peles, F.; Sipos, P.; Kovács, S.; Győri, Z.; Pócsi, I.; Pusztahelyi, T. Biological control and mitigation of aflatoxin contamination in commodities. Toxins 2021, 13, 104. [Google Scholar] [CrossRef]
- Nasrollahzadeh, A.; Mokhtari, S.; Khomeiri, M.; Saris, P. Mycotoxin detoxification of food by lactic acid bacteria. Int. J. Food Contam. 2022, 9, 1. [Google Scholar] [CrossRef]
- Hathout, A.; Abdel-Nasser, A. The efficiency of Saccharomyces cerevisiae as an antifungal and antimycotoxigenic agent. Biointerface Res. Appl. Chem. 2023, 13, 354. [Google Scholar]
- Zhao, M.; Liu, D.; Liang, Z.; Huang, K.; Wu, X. Antagonistic activity of Bacillus subtilis CW14 and its β-glucanase against Aspergillus ochraceus. Food Cont. 2022, 131, 108475. [Google Scholar] [CrossRef]
- Khan, M.S.; Gao, J.; Chen, X.; Zhang, M.; Yang, F.; Du, Y.; Moe, T.S.; Munir, I.; Xue, J.; Zhang, X. The Endophytic Bacteria Bacillus velezensis Lle-9, Isolated from Lilium leucanthum, Harbors Antifungal Activity and Plant Growth-Promoting Effects. J. Microbiol. Biotechnol. 2020, 30, 668–680. [Google Scholar] [CrossRef]
- Tobin-West, M.; Dimkpa, S.; Osakwe, J. Isolation and identification of fungi associated with raw groundnut seeds sold at four major markets in Port Harcourt Metropolis, Rivers State. Biol. Agric. Health 2018, 8, 29–34. [Google Scholar]
- Ncube, J.; Ndlovu, E.; Musarandega, L.; Maphosa, M. Occurrence of mycoflora, their association and production of aflatoxin B1 in groundnuts. J. Yeast Fungal Res. 2021, 12, 1–7. [Google Scholar]
- Rajarajan, P.; Sylvia, K.; Periasamy, M.P.; Subramanian, M. Detection of aflatoxin producing Aspergillus flavus from animal feed in Karnataka, India. Environ. Anal. Health Toxicol. 2021, 36, e2021017. [Google Scholar] [CrossRef]
- De Lima, D.J.; Monteiro Riboldi, P.H.; Rivadaea, R.W.; Barbosa, M.; Cordeiro, D.R.; Garboggini, F.F.; Auer, G.; da Silva, J.G. Potential of endophytic bacteria from Acacia mearnsii: Phosphate solubilization, indole acetic acid production, and application in wheat. Appl. Soil Ecol. 2024, 196, 105315. [Google Scholar] [CrossRef]
- Idiyatov, I.I.; Eroshin, A.I.; Yusupov, S.A.; Zdoroveva, E.V.; Tremasova, A.M. Endophytic isolates of Bacillus subtilis: Prospects of application for improving the quality of food raw materials. IOP Conf. Ser. Earth Environ. Sci. 2021, 953, 012024. [Google Scholar] [CrossRef]
- Petrović, M.; Janakiev, T.; Ljaljević Grbić, M.; Nikola Unković, N.; Stević, T.; Vukićević, S.; Dimkić, I. Insights into endophytic and rhizospheric bacteria of five sugar beet hybrids in terms of their diversity, plant-growth promoting, and biocontrol properties. Microbial Ecol. 2024, 87, 19. [Google Scholar] [CrossRef]
- Devi, K.A.; Pandey, G.; Rawat, A.K.S.; Sharma, G.D.; Pandey, P. The Endophytic Symbiont-Pseudomonas aeruginosa Stimulates the Antioxidant Activity and Growth of Achyranthes aspera L. Front. Microbiol. 2017, 8, 1897. [Google Scholar]
- Patel, J.K.; Mistry, Y.; Soni, R.; Jha, A. Evaluation of antifungal activity of endophytic Bacillus spp. and identification of secondary metabolites produced against the phytopathogenic fungi. Curr. Microbiol. 2024, 81, 128. [Google Scholar] [CrossRef] [PubMed]
- Nanda, S.; Mohanty, B.; Joshi, R.K. Endophyte-mediated host stress tolerance as a means for crop improvement. In Endophytes and Secondary Metabolites; Springer: Cham, Switzerland, 2019; pp. 677–701. [Google Scholar]
- Gajbhiye, M.; Kapadnis, B. Lactococcus lactis subsp. cremoris of plant origin produces antifungal cyclo-(leu-pro) and tetradecanoic acid. Indian J. Microbiol. 2021, 61, 74–80. [Google Scholar]
- Bukhari, S.A.; Salman, M.; Numan, M. Characterization of antifungal metabolites produced by Lactobacillus plantarum and Lactobacillus coryniformis isolated from rice rinsed water. Mol. Biol. Rep. 2020, 47, 1871–1881. [Google Scholar] [CrossRef]
- Dos Reis, C.M.; da Rosa, B.V.; da Rosa, G.P. Antifungal and antibacterial activity of extracts produced from Diaportheschini. J. Biotechnol. 2019, 294, 30–37. [Google Scholar] [CrossRef]
- Mulatu, A.; Megersa, N.; Tolcha, T. Antifungal compounds, GC-MS analysis and toxicity assessment of methanolic extracts of Trichoderma species in an animal model. PLoS ONE 2022, 17, e0274062. [Google Scholar] [CrossRef]
- Prakash, P.; Vijayasarathi, D.; Selvam, K. Pharmacoremaping based on docking, ADME/toxicity, virtual screening on 3,5-dimethyl-1,3,4-hexanetriol and dodecanoic acid derivates for anticancer inhibitors. J. Biomol. Struct. Dyn. 2021, 39, 4490–4500. [Google Scholar] [CrossRef]
- Wang, K.; Yan, P.; Ding, Q.; Wu, Q.; Wang, Z.; Peng, J. Diversity of culturable root-associated/endophytic bacteria and their chitinolytic and aflatoxin inhibition activity of peanut plant in China. World J. Microbiol. Biotechnol. 2013, 29, 1–10. [Google Scholar] [CrossRef]
- Campos-Avela, I.; Noue, A.C.; Durand, N.; Cazals, G.; Martinez, V.; Strub, C.; Fontana, A.; Schorr-Galindo, S. Aspergillus flavus growth inhibition and aflatoxin B1 decontamination by Streptomyces isolates and their metabolites. Toxins 2021, 13, 340. [Google Scholar] [CrossRef]
- Jard, G.; Liboz, T.; Mathieu, F.; Guyonvarc’h, A.; Lebrihi, A. Review of mycotoxin reduction in food and feed: From prevention in the field to detoxification by adsorption or transformation. Food Add. Contam. Part A 2011, 28, 1590–1609. [Google Scholar] [CrossRef]
- Wang, W.; Yan, B.; Xu, W.; Qiu, Y.; Guo, Y.; Qiu, Z. Highly selective bioconversion of ginsenoside Rb1 to compound K by the mycelium of Cordyceps sinensis under optimized conditions. Molecules 2015, 20, 19291–19309. [Google Scholar] [CrossRef] [PubMed]
- Shkula, S.; Park, J.H.; Chung, S.H.; Kim, M. Ochratoxin A reduction ability of biocontrol agent Bacillus subtilis isolated from Korean traditional fermented food Kimchi. Sci. Rep. 2018, 8, 1–10. [Google Scholar] [CrossRef] [PubMed]
- Yassein, A.S.; Elamary, R.B. Efficacy of soil Paraburkholderia fungorum and Bacillus subtilis on the inhibition of Aspergillus niger growth and its ochratoxins production. Egypt. J. Bot. 2021, 61, 319–334. [Google Scholar] [CrossRef]
- Yang, P.; Wu, W.; Zhang, D.; Cao, L.; Cheng, J. AFB1 microbial degradation by Bacillus subtilis WJ6 and its degradation mechanism exploration based on the comparative transcriptomics approach. Metabolites 2023, 13, 785. [Google Scholar] [CrossRef]
- Xu, Y.; Zhao, R.; Liu, C. Degradation of Aflatoxin B1 in Moldy Maize by Pseudomonas aeruginosa and Safety Evaluation of the Degradation Products. Foods 2023, 12, 1217. [Google Scholar] [CrossRef]
- Sánchez-Arroyo, A.; Plaza-Vinuesa, L.; Abeijón-Mukdsi, M.C.; de las Rivas, B.; Mancheño, J.M.; Muñoz, R. A new and promiscuous α/β hydrolase from Acinetobacter tandoii DSM 14970 T inactivates the mycotoxin ochratoxin A. Appl. Microbiol. Biotechnol. 2024, 108, 230. [Google Scholar] [CrossRef]

| Location | Medicinal Plant | No. of Colonies Developed on CNAM | |||
|---|---|---|---|---|---|
| Common Name | Arabic Name | Scientific Name | Sphere | ||
| Aswan | Argel | الحرجل | Solenostemma argel | Endorhizosphere | 4 |
| Aswan | Roselle | الكركديه | Hibiscus sabdariffa | Endophyllosphere | 10 |
| El-Alamein | Ginseng | الجنسنج | Panax quinquefolius | Endophyllosphere | 2 |
| El-Arish | Drum sticks | المورينجا | Moringa oleifera | Endorhizosphere | 9 |
| El-Minia | Ginger | الزنجبيل | Zingiber officinale | Endorhizosphere | 0 |
| Giza | Basil | ريحان | Ocimum basilicum | Endorhizosphere | 8 |
| Giza | Rue | الحرمل | Peganum harmala | Endophyllosphere | 4 |
| Giza | Spearmint | النعناع | Mentha viridis | Endorhizosphere | 0 |
| Giza | Thyme | الزعتر | Thymus vulgaris | Endorhizosphere | 5 |
| Ismailia | Ginseng | الجنسنج | Panax quinquefolius | Endophyllosphere | 2 |
| Matrouh | Rosemary | روزماري | Rosmarinus officinalis | Endorhizosphere | 7 |
| North Sinai | Sage | المريميه | Salvia officinalis | Endorhizosphere | 3 |
| Sohag | Cumin | الكمون | Cuminum cyminum | Endorhizosphere | 6 |
| Treatments | Control | Aspergillus spp. Isolates | Endophyte Isolates | |||
|---|---|---|---|---|---|---|
| Be13 | Sa1 | Ar10 | Ma27 | So34 | ||
| Control | * | |||||
| A | * | |||||
| B | * | |||||
| C | * | |||||
| D | * | |||||
| E | * | |||||
| F | * | * | ||||
| G | * | * | ||||
| H | * | * | ||||
| I | * | * | ||||
| J | * | * | ||||
| K | * | * | ||||
| Isolate Code * | Aflatoxin B1 | Ochratoxin A | ||
|---|---|---|---|---|
| Concentrations (µg/mL) | Retention Time (min) | Concentrations (µg/mL) | Retention Time (min) | |
| AS3 | 439.89 | 3.077 | - | - |
| AS5 | - | - | 1.01 | 2.273 |
| Be4 | - | - | 1.66 | 2.297 |
| Bi3 | - | - | 2.48 | 2.430 |
| Be7 | - | - | 0.88 | 2.317 |
| Be13 | 1859.18 | 2.797 | - | - |
| Bi2 | 304.91 | 2.027 | - | - |
| Ca3 | 696.92 | 3.050 | - | - |
| Da1 | - | - | 1.02 | 2.137 |
| Fa2 | - | - | 1.17 | 2.370 |
| Gi3 | 586.34 | 3.190 | - | - |
| Gi5 | - | - | 1.64 | 2.123 |
| Hu1 | - | - | 0.96 | 2.553 |
| Hu3 | 687.19 | 3.187 | - | - |
| Is2 | - | - | 3.67 | 2.287 |
| Is4 | 280.40 | 2.880 | - | - |
| Ob1 | 322.08 | 2.797 | - | - |
| Sa1 | - | - | 6.00 | 2.283 |
| Sa6 | 371.70 | 2.713 | - | - |
| So2 | 1162.74 | 3.053 | - | - |
| Endophytic Isolate Codes | Aspergillus novoparasiticus Be13 | Aspergillus ochraceus Sa1 | ||
|---|---|---|---|---|
| Diameter of Inhibition Zone (mm) | Fungal Inhibition (%) | Diameter of Inhibition Zone (mm) | Fungal Inhibition (%) | |
| Al1 | 3 ± 0.14 | 3.33 | 14 ± 0.07 | 17.50 |
| Al2 | 6 ± 0.11 | 6.67 | 2 ± 0.22 | 2.50 |
| Ar3 | 5 ± 0.15 | 5.56 | 8 ± 0.03 | 10.00 |
| Ar4 | 10 ± 0.15 | 11.11 | 0.00 ± 0.00 | 0 |
| Ar5 | 7 ± 0.52 | 7.78 | 8 ± 0.07 | 10.00 |
| Ar6 | 19 ± 0.23 | 21.11 | 15 ± 0.14 | 18.75 |
| As7 | 10 ± 0.28 | 11.11 | 11.4 ± 0.07 | 14.25 |
| As8 | 5 ± 0.29 | 5.56 | 2 ± 0.14 | 2.50 |
| As9 | 8 ± 0.49 | 8.89 | 7 ± 0.35 | 8.75 |
| As10 | 10.2 ± 0.21 | 11.33 | 9 ± 0.14 | 11.25 |
| Gi11 | 4 ± 0.14 | 4.44 | 7.2 ± 0.28 | 9.00 |
| Gi12 | 2 ± 0.16 | 2.22 | 13 ± 0.44 | 16.25 |
| Gi13 | 6 ± 0.84 | 6.67 | 12 ± 0.53 | 15.00 |
| Gi14 | 9 ± 0.04 | 10 | 5 ± 0.40 | 6.25 |
| Gi15 | 9 ± 0.29 | 10 | 3 ± 0.22 | 3.75 |
| Gi16 | 0 ± 0.00 | 0 | 8 ± 0.28 | 10.00 |
| Gi17 | 5 ± 0.93 | 5.56 | 3 ± 0.14 | 3.75 |
| Gi18 | 1.6 ± 0.27 | 1.78 | 9 ± 0.24 | 11.25 |
| Gi19 | 2 ± 0.52 | 2.22 | 5 ± 0.30 | 6.25 |
| Gi 20 | 6 ± 0.30 | 6.67 | 12 ± 0.28 | 15.00 |
| Gi 21 | 2 ± 0.28 | 2.22 | 3 ± 0.05 | 3.75 |
| Is 22 | 4 ± 0.15 | 4.44 | 7 ± 0.35 | 8.75 |
| Is 23 | 3 ± 0.18 | 3.33 | 9 ± 0.44 | 11.25 |
| Ma24 | 7 ± 0.16 | 7.78 | 11 ± 0.04 | 13.75 |
| Ma 25 | 6 ± 0.39 | 6.67 | 0 ± 0.00 | 0 |
| Ma 26 | 9 ± 0.42 | 10 | 10 ± 0.49 | 12.50 |
| Ma 27 | 12 ± 0.03 | 13.33 | 18 ± 0.07 | 22.50 |
| Ma 28 | 3 ± 0.08 | 3.33 | 6 ± 0.06 | 7.50 |
| No 29 | 2 ± 0.13 | 2.22 | 3 ± 0.02 | 3.75 |
| No30 | 5 ± 0.63 | 5.56 | 19 ± 0.13 | 23.75 |
| No31 | 0 ± 0.00 | 0 | 6 ± 0.44 | 7.50 |
| So32 | 4 ± 0.29 | 4.44 | 3 ± 0.54 | 3.75 |
| So33 | 10 ± 0.01 | 11.11 | 16 ± 0.60 | 20.00 |
| So34 | 10 ± 0.23 | 11.11 | 26 ± 0.07 | 32.50 |
| So35 | 5 ± 0.13 | 5.56 | 9 ± 0.42 | 11.25 |
| So36 | 3 ± 0.14 | 3.33 | 10 ± 0.39 | 12.50 |
| Bioactivity | P. aeruginosa Ar6 | B. subtilis Ma27 | B. velezenesis So34 |
|---|---|---|---|
| Indole acetic acid (µg/100 mL) | 16.94 ± 0.07 | 37.79 ± 1.24 | 79.66 ± 0.027 |
| Phosphate solubilization (µg/100 mL) | 21.38 ± 0.04 | 17.13 ± 0.34 | 2.50 ± 0.03 |
| Polysaccharides (mg mL−1) | 4.33 ± 0.23 | 6.57 ± 0.35 | 2.74 ± 0.16 |
| HCN production | +++ | - | +++ |
| Treatments | Shoot (Sh) | Root (R) | R/Sh (DW Bases) | ||
|---|---|---|---|---|---|
| Fresh Weight (g plant−1) | Dry Weight (g plant−1) | Fresh Weight (g plant−1) | Dry Weight (g plant−1) | ||
| Control | 2.67 ± 0.01 f | 0.53 ± 0.01 i | 1.24 ± 0.03 e | 0.23 ± 0.01 h | 0.43 |
| A. novoparasiticus | −70.0 ± 0.01 h | −84.9 ± 0.01 k | −83.9 ± 0.02 g | −95.7 ± 0.01 j | 0.13 |
| A. ochraceus | −27.7 ± 0.02 g | −71.7 ± 0.01 j | −29.8 ± 0.11 f | −78.3 ± 0.021 i | 0.33 |
| P. aeruginosa | +93.6 ± 0.25 b | +354.7 ± 0.02 c | +71.0 ± 0.35 b | +308.7 ± 0.04 b | 0.39 |
| B. subtilis | +97.8 ± 0.23 b | +384.9 ± 0.03 b | +95.2 ± 0.23 a | +347.8 ± 0.01 a | 0.40 |
| B. velezensis | +152.1 ± 0.14 a | +398.1 ± 0.02 a | +112.1 ± 0.06 a | +360.9 ± 0.01 a | 0.40 |
| A. novoparasiticus + P. aeruginosa | +31.5 ± 0.14 e | +56.6 ± 0.03 h | +32.3 ± 0.03 d | +13.0 ± 0.02 gh | 0.31 |
| A. novoparasiticus + B. subtilis | +75.7 ± 0.04 d | +122.6 ± 0.01 g | +50.0 ± 0.06 bcd | +121.7 ± 0.04 f | 0.43 |
| A. novoparasiticus + B. velezensis | +83.9 ± 0.05 c | +184.9 ± 0.05 d | +65.3 ± 0.34 bc | +230.4 ± 0.15 e | 0.50 |
| A. ochraceus + P. aeruginosa | +34.5 ± 0.07 e | +62.3 ± 0.01 h | +43.5 ± 0.09 cd | +21.7 ± 0.06 g | 0.33 |
| A. ochraceus + B. subtilis | +81.3 ± 0.02 cd | +158.5 ± 0.01 f | +51.6 ± 0.13 bcd | +139.1 ± 0.07 e | 0.40 |
| A. ochraceus + B. velezensis | +82.8 ± 0.10 cd | +169.8 ± 0.01 e | +58.1 ± 0.02 bc | +173.9 ± 0.02 d | 0.44 |
| L.S.D (p < 0.05) | 0.2 | 0.1 | 0.3 | 0.1 | |
| CV% | 2.1 | 2.8 | 6.3 | 7.4 | |
Disclaimer/Publisher’s Note: The statements, opinions and data contained in all publications are solely those of the individual author(s) and contributor(s) and not of MDPI and/or the editor(s). MDPI and/or the editor(s) disclaim responsibility for any injury to people or property resulting from any ideas, methods, instructions or products referred to in the content. |
© 2025 by the authors. Licensee MDPI, Basel, Switzerland. This article is an open access article distributed under the terms and conditions of the Creative Commons Attribution (CC BY) license (https://creativecommons.org/licenses/by/4.0/).
Share and Cite
Helal, N.I.M.; Badawi, M.H.; El-Hadidy, A.M.; Agha, M.K.M.; Abou-Shady, A.; Fayez, M. Endophytic Microbiome Is a Unique Repository of Bio-Foes Against Toxigenic Fungi Harming Peanut Productivity. Microbiol. Res. 2025, 16, 141. https://doi.org/10.3390/microbiolres16070141
Helal NIM, Badawi MH, El-Hadidy AM, Agha MKM, Abou-Shady A, Fayez M. Endophytic Microbiome Is a Unique Repository of Bio-Foes Against Toxigenic Fungi Harming Peanut Productivity. Microbiology Research. 2025; 16(7):141. https://doi.org/10.3390/microbiolres16070141
Chicago/Turabian StyleHelal, Nagwa I. M., Mona H. Badawi, Abeer M. El-Hadidy, Mohamed K. M. Agha, Ahmed Abou-Shady, and Mohamed Fayez. 2025. "Endophytic Microbiome Is a Unique Repository of Bio-Foes Against Toxigenic Fungi Harming Peanut Productivity" Microbiology Research 16, no. 7: 141. https://doi.org/10.3390/microbiolres16070141
APA StyleHelal, N. I. M., Badawi, M. H., El-Hadidy, A. M., Agha, M. K. M., Abou-Shady, A., & Fayez, M. (2025). Endophytic Microbiome Is a Unique Repository of Bio-Foes Against Toxigenic Fungi Harming Peanut Productivity. Microbiology Research, 16(7), 141. https://doi.org/10.3390/microbiolres16070141

